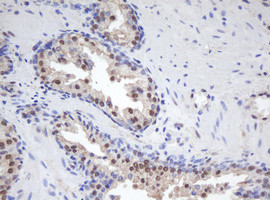
MORF4 Antibody in Immunohistochemistry (Paraffin) (IHC (P))

Search
OriGene
MORF4 Monoclonal Antibody (OTI1B12), TrueMAB™
{{$productOrderCtrl.translations['antibody.pdp.commerceCard.promotion.promotions']}}
{{$productOrderCtrl.translations['antibody.pdp.commerceCard.promotion.viewpromo']}}
{{$productOrderCtrl.translations['antibody.pdp.commerceCard.promotion.promocode']}}: {{promo.promoCode}} {{promo.promoTitle}} {{promo.promoDescription}}. {{$productOrderCtrl.translations['antibody.pdp.commerceCard.promotion.learnmore']}}
产品信息
TA800382
种属反应
宿主/亚型
分类
类型
克隆号
抗原
偶联物
形式
浓度
纯化类型
保存液
内含物
保存条件
运输条件
靶标信息
Cellular senescence is the terminal non-dividing state that normal cells enter following completion of their proliferative potential. Fusions of immortal human cell lines with each other have led to their assignment to one of four complementation groups. Mortality factor 4 (MORF4) was identified as the lead member of a family of transcription factor-like proteins that reverses this immortal phenotype. Like other members in this family, MORF4 is localized to the nucleus and possesses transcription factor-like motifs such as helix-loop-helix and a leucine zipper motif that might allow it to form transcriptionally active homo- or heterodimers. MORF4 has been shown to bind to the transcription corepressors mSin3A and TLE, suggesting that together, these complexes may play a role in transcriptional repression of genes that lead to cellular senescence.
仅用于科研。不用于诊断过程。未经明确授权不得转售。
篇参考文献 (0)
生物信息学
蛋白别名: csrb; SEN1